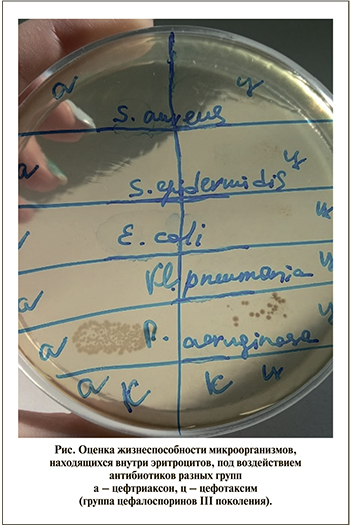

Введение. Инфекционно-воспалительные заболевания в урологии и вопросы их лечения, профилактики представляют собой одну из наиболее актуальных проблем современной медицины [1, 2], а также большое внимание уделяется возбудителям, способным к длительной внутриклеточной персистенции [3].
В лечении острого пиелонефрита ведущее значение имеет антибактериальная терапия, которую подобрать адекватно можно после идентификации возбудителя и определения его чувствительности к антибиотикам. На начальном этапе успех в лечении острого пиелонефрита зависит от правильного эмпирического подбора антибактериального лечения. Для адекватной антибактериальной терапии важно выбрать антибиотик, с одной стороны, действующий на «проблемные» микроорганизмы, с другой – накапливающийся в почках в необходимой концентрации [4, 5].
Для больных урогенитальными инфекциями весьма актуальна проблема резистентности микроорганизмов к антибактериальным препаратам. Невозможно вылечить пациента с острым вторичным пиелонефритом, если свое-временно не восстановить уродинамику. Но в то же время наличие дренажей приводит к катетер-ассоциированной инфекции. Возникает порочный круг: без дренирования мочевых путей в большинстве случаев невозможно проводить адекватную антибактериальную терапию, эффективность которой снижается из-за дренажей, создающих условия для формирования биопленок. Поэтому в лечении больных гнойным пиелонефритом нужно использовать препараты с расширенным спектром антибактериальной активности, резистентность к которым основных возбудителей пиелонефрита отсутствует или находится на достаточно низком уровне [6]. При гнойном пиелонефрите стартовая эмпирическая терапия назначается парентерально сразу же после дренирования мочевыводящих путей и гнойных очагов в почке [7].
Известны работы, в которых описываются механизмы проникновения патогенов внутрь клеток, в частности нахождение бактерий внутри эритроцитов, например Brucella melitensis [8], Streptococcus pneumoniaе [9], Staphylococcus epidermidis [10]. В работах авторов Е. А. Щупловой и соавт. [11] были представлены данные о нахождении адгезированных на поверхности эритроцитов и внутриэритроцитарно расположенных бактерий в крови больных гнойной стадией острого пиелонефрита. Вопрос о влиянии антибактериальных препаратов на бактерии, находящиеся внутри эритроцитов, мало изучен.
Цель исследования: изучить антибиотикочувствительность штаммов микроорганизмов, выделенных от больных гнойной стадией острого пиелонефрита, находящихся внутри эритроцитов.
Материалы и методы. В экспериментальной работе использовали 15 штаммов гемокультур, выделенных из крови больных гнойной стадией острого пиелонефрита. Для обнаружения и выделения микроорганизмов в крови обследуемых больных использовали как классический бактериологический, так и современный молекулярно-генетический метод – флуоресцентная in situ гибридизация, которая одновременно с обнаружением позволяет проводить идентификацию [11]. Параллельно идентификацию выделенных гемокультур проводили с использованием тест-систем: Enterotest-24, Staphytest, Nefermtest-24 («Lachema», Чехия). После проведенной идентификации оказалось, что 15 гемокультур относились к 5 видам микроорганизмов: Staphylococcus aureus (2 штамма), S. epidermidis (1 штамм), Escherichia coli (8 штаммов), Klebsiella pneumoniae (1 штамм) и Pseudomonas aeruginosa (3 штамма).
При создании модели «эритроциты–бактерии» (in vitro) для внутриэритроцитарной локализации микроорганизмов использовали кровь донора, которую центрифугировали в течение 10 мин при 1500 g, плазму и верхний слой осевших клеток, содержащий лейкоциты и тромбоциты, удаляли, а оставшиеся эритроциты дважды отмывали путем ресуспендирования в двойном объеме изотонического фосфатно-солевого буферного раствора (ФСБ) (рН=7,2). Далее 2 мл эритроцитарной взвеси фильтровали через крупнопористые фильтры для грубых крупнодисперсных осадков и добавляли к осадку 18 мл ФСБ для получения 5%-ной эритроцитарной взвеси (или 106 эр/мл)).
Затем к 0,5 мл эритроцитарной взвеси добавляли 0,5 мл взвеси исследуемых микроорганизмов на физиологическом растворе в концентрации 109 КОЕ/мл и 0,2 мл питательной среды RPMI – 1640 (ООО «БиолоТ», Санкт-Петербург). Параллельно готовили контрольные пробы – 0,5 мл эритроцитарной взвеси смешивали с 0,5 мл физиологического раствора и добавляли 0,2 мл питательной среды RPMI – 1640 (ООО «БиолоТ», Санкт-Петербург). Опытные и контрольные образцы инкубировали в термостате при 370С в течение 24 ч. По результатам ранее проведенных исследований известно, что в течение 24 ч инкубации при 370С происходит внутриэритроцитарная локализация исследуемых микроорганизмов [12].
При изучении антибиотикочувствительности внутри-эритроцитарно локализованных штаммов микроорганизмов использовали метод доставки антибиотиков во внутрь эритроцитов (метод ступенчатого лизиса) [13].
При ступенчатом лизисе «зараженные» эритроциты сначала помещали в 400 мкл 0,7%-ного раствора NaCl при t=100C, тоничность которого достаточно низка для того, чтобы вызывать значительное набухание клеток, но недостаточно низка для того, чтобы приводить к лизису клеток. После короткой инкубации (2–3 мин) «зараженные» эритроциты отделяли от среды центрифугированием при 1000 об/мин в течение 4 мин и смешивали с эквивалентным объемом гипотонической среды, вызывающей лизис клеток и содержащей вводимые в эритроциты растворы антибактериальных препаратов. Смешивали опытные и контрольные образцы при t=100C с 400 мкл 0,5%-ного раствора NaCl, содержащего 500 мг/мл исследуемых различных групп антибиотиков.
В данной работе использовали следующие группы антибактериальных препаратов, использующих для лечения больных острым пиелонефритом макролиды, фторхинолоны, аминогликозиды, цефалоспорины III, цефалоспорины III поколения с ингибитором бета-лактамаз, а также группа производной фосфоновой кислоты.
После короткой инкубации (5 мин) тоничность среды доводили до нормального значения (до 0,9%-ного раствора NaCl), а температуру до 370C. При такой процедуре эффективность включения препаратов в эритроциты теоретически может достигать 50%, поскольку соотношение объемов клеток и лизирующей среды составляет 1:1. По этой же причине метод ступенчатого лизиса снижает потери содержимого эритроцитов и приводит к большей жизнеспособности эритроцитов-переносчиков.
После введения исследуемых антибиотиков в «зараженные» эритроциты опытные и контрольные пробы инкубировали в термостате при 370 С в течение 4 часов, далее пробы отмывали ФСБ (рН=7,2) центрифугированием в течение 5 мин при 1000 g.
На следующем этапе данного исследования для контроля жизнеспособности внутриэритроцитарных бактерий, после воздействия антибиотиков, в опытные образцы добавляли 400 мкл стерильной дистиллированной воды, затем лизированный раствор исследуемых эритроцитов высевали на мясо-пептонный агар и через 24 часа инкубации при 370С производили учет результатов.
В данном исследовании у всех исследуемых штаммов микроорганизмов, выделенных от больных гнойной стадией острого пиелонефрита, была параллельно определена антибиотикочувствительность к используемым в работе антибиотикам. Для этого к 1 мл взвеси исследуемых микроорганизмов на физиологическом растворе в концентрации 109 КОЕ/мл добавили 0,5%-ный раствор NaCl в объеме 400 мкл, содержащий 500 мг/мл исследуемых антибактериальных препаратов. Все исследования проводили в троекратных повторах.
Результаты. В результате данного исследования из образцов крови больных гнойной стадией острого пиелонефрита выделено 15 штаммов различных видов микроорганизмов – Staphylococcus aureus, S.epidermidis, Escherichia coli, Klebsiella pneumoniae и Pseudomonas aeruginosa. В данной работе для обнаружения микроорганизмов в образцах крови обследуемых больных использовали как классический бактериологический, так и современный молекулярно-генетический метод флуоресцентной in situ гибридизации (FISH). Конечно, недостатком бактериологического метода является длительность культивирования посевов до 5–7 сут., длительное время для идентификации чистой культуры с помощью различных биохимических тестов, но для дальнейшей работы нам необходимо было выделить гемокультуру.
В отличие от бактериологического метода чувствительность метода FISH составляет 95% [14], время для исследований сокращается до 8–12 ч. Метод FISH позволяет одновременно проводить идентификацию микроорганизмов, так как ДНК и рРНК бактерий гибридизуются с ДНК-зондами, комплементарными таксонспецифическими участками гена 16S рРНК [14]. Однако метод FISH,в отличие от бактериологического метода не позволяет получать гемокультуру из образцов крови больных гнойной стадией острого пиелонефрита и изучать антибиотикочувствительность обнаруженных в крови микроорганизмов.
В связи с высокой устойчивостью микроорганизмов к антибактериальным препаратам у больных гнойной формой острого пиелонефрита и полученными результатами о нахождении микроорганизмов внутри эритроцитов авторы данного исследования решили изучить вопрос антибиотикочувствительности штаммов микроорганизмов, находящихся внутри эритроцитов. В решении данного вопроса использовали метод доставки антибактериальных препаратов внутрь эритроцитов [13].
Влияние антибиотиков на жизнеспособность бактерий внутри эритроцитов оценивали по ростовым характеристикам (см. рисунок).
В результате проведенных исследований по определению антибиотикочувствительности бактерий, находящихся внутри эритроцитов, получены данные, представленные в таблице.

По результатам таблицы необходимо отметить то, что в 70±3,4% случаев золотистый стафилококк, находившийся внутри эритроцитов, был чувствителен ко всем исследуемым антибиотикам, кроме левофлоксацина, амикацина и фосфомицина. К данным препаратам наблюдали резистентность. Необходимо отметить, что чувствительность S.aureus к данным препаратам вне эритроцитов составляла 100%. Аналогичные результаты получили при изучении антибиотикочувствительности S.epidermidis, находящейся внутри эритроцитов.
Представители семейства Enterobacteriaceae – E. coli, Kl. pneumoniae (грамотрицательные микроорганизмы) оказались в 60±3,5% случаев чувствительными к антибиотикам группы аминогликозидов и цефалоспоринов III поколения. К антибактериальным препаратам группы фторхинолонов, макролидов и производной фосфоновой кислоты E. coli и Kl. pneumoniae оказались резистентными. Вне эритроцитов у данных штаммов микроорганизмов в 100% случаев отмечали чувствительность к исследуемым группам антибактериальных препаратов.
У P. аeruginosa, выделенных от больных гнойной формой острого пиелонефрита, наблюдали резистентность к антибактериальным препаратам группы фторхинолоны и макролиды, а при изучении влияния антибиотиков на P. аeruginosa, находившихся внутри эритроцитов (in vitro), резистентность отмечали еще и к группам антибактериальных препаратов производных фосфоновой кислоты, цефалоспоринов III поколения. При нахождении P. аeruginosa внутри эритроцитов резистентность к исследуемым антибиотикам наблюдали в 80±3,2% случаев относительно контрольных значений.
Аналогичные результаты получены при изучении влияния вариантов комбинации антибактериальных препаратов на штаммы микроорганизмов, выделенных от больных гнойной стадией острого пиелонефрита, впоследствии нахоившихся внутри эритроцитов.
Таким образом, результаты данного исследования показали, что микроорганизмы, выделенные от больных гнойной стадией острого пиелонефрита и впоследствии находившихся внутри эритроцитов (эксперимент in vitro) в 80% случаев оказались резистентными к антибактериальным препаратам разных групп (фторхинолоны, аминогликозиды, макролиды, производные фосфоновой кислоты). Вне эритроцитов утех же исследуемых микроорганизмов наблюдали антибиотикочувствительность к препаратам, используемым в работе. По всей видимости, можно рассматривать вариант устойчивости к антибиотикам уропатогенов, находящихся внутри эритроцитов, как результат недостаточной внутриэритроцитарной концентрации антибиотика даже при его доставке методом ступенчатого лизиса.
Обсуждение. Проблема антибактериальной терапии больных острым пиелонефритом на сегодняшний день остается актуальной. Во-первых, это связано с множественной резистентностью микроорганизмов к антибактериальным препаратам [15]. Во-вторых, микроорганизмы способны вырабатывать стратегии ухода бактерий от действия антибиотиков, описанных в литературных источниках [16]. Гетерорезистентность и персистентность – стратегии укрытия бактерий от воздействия антибактериальных препаратов, при которых только часть клеток проявляют устойчивость или толерантность (способность переживать) к воздействию конкретного антибиотика при фенотипической чувствительности исследуемой бактериальной культуры [16].
По данным литературы известно, что многие микроорганизмы способны проникать внутрь эритроцитов и сохранять свою жизнеспособность [8–10]. Результаты предыдущих исследований показали, что с помощью современного молекулярно-генетического метода флуоресцентной in situ гибридизации у пациентов с гнойной формой острого пиелонефрита в крови были обнаружены адгезированные на поверхности эритроцитов и внутриэритроцитарно расположенных бактерий [11]. Авторы данного исследования предполагают, что, возможно, это еще одна стратегия уклонения бактерий от действия антибиотиков и развития антибиотикорезистентности.
Результаты данного исследования (in vitro) показали, что микроорганизмы – представители семейства Enterobacteriaceae, Staphylococcаceae, а также P. aeruginosa, находящиеся внутри эритроцитов, оказались резистентными к антибактериальным препаратам группы фторхинолонов. Подтверждение полученных результатов отображаются в работе В. В. Рафальского и Е. В. Довганя [17], где авторы отмечают значительный рост уровня антибиотикорезистентности E. coli к фторхинолонам, которые до середины прошлого десятилетия являлись «золотым» стандартом в лечении инфекций мочевыводящих путей. Частота устойчивости к фторхинолонам в России, по данным последнего исследования («ДАРМИС-2», 2018), превышает для Enterobacteriaceae 27,1%, E. coli 26%, поэтому они не рекомендуются как препараты первого выбора [18]. В работе Л. А. Синяковой [7] также отмечен рост микроорганизмов, резистентных к фторхинолонам, и для лечения тяжелых больных с гнойно-деструктивными формами острого калькулезного пиелонефрита назначаются препараты карбапенемы второй группы – имипенем, меропенем, дорипенем.
В результате данного исследования у микроорганизмов, выделенных от больных гнойной стадии острого пиелонефрита, обнаружили резистентность к антибактериальным препаратам группы производной фосфоновой кислоты (фосфомицин), аминогликозидов, в частности к амикацину у S. aureus и S. epidermidis и к антибиотику азитромицину группы макролидов у представителей семейства Enterobacteriaceae. Причем необходимо отметить, что резистентность к антибиотикам наблюдали у исследуемых штаммов, находящихся внутри эритроцитов (in vitro). Вне эритроцитов у данных микроорганизмов наблюдали чувствительность к антибактериальным препаратам.
Исходя из полученных результатов, авторы данного исследования предполагают, что «укрытие» бактерий в эритроцитах крови больных гнойной стадией острого пиелонефрита может приводить к развитию антибиотикорезистентности у микроорганизмов, а также способствовать переходу острого инфекционного процесса в хронический или развитию уросепсиса.
Необходимо отметить, что данные о чувствительности штаммов к антибиотикам (in vitro) не всегда коррелируют с результатами лечения, возможно, это связано с критериями оценки минимальной подавляющей концентрации штамма, основывающейся в основном на сывороточных концентрациях препарата [19]. Изучение чувствительности микроорганизмов in vitro является крайне упрощенной моделью инфекционного процесса, происходящего в организме человека. Основной целью использования подобной модели служит прогнозирование клинической эффективности антимикробной терапии [17].
Заключение. Таким образом, при лечении больных острым пиелонефритом в стадии гнойного воспаления необходимо учитывать тот факт, что микроорганизмы могут проникать внутрь эритроцитов. Эксперименты in vitro показали, что у микроорганизмов, находящихся внутри эритроцитов, наблюдается антибиотикорезистентность к антибактериальным препаратам разных групп.
Необходимо дальнейшее изучение по внутриэритроцитарному расположению микроорганизмов при гнойной стадии острого пиелонефрита как нового звена в патогенезе развития заболевания. Возможно, полученные новые результаты могут привести к пересмотру принципов антибактериальной терапии.



